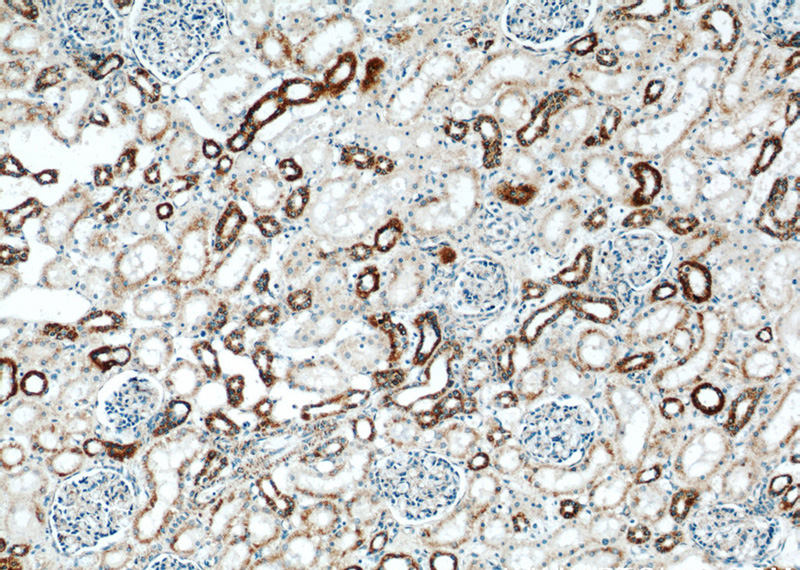
Immunohistochemistry of paraffin-embedded human kidney slide using Catalog No:108350(ATP5A1 Antibody) at dilution of 1:50
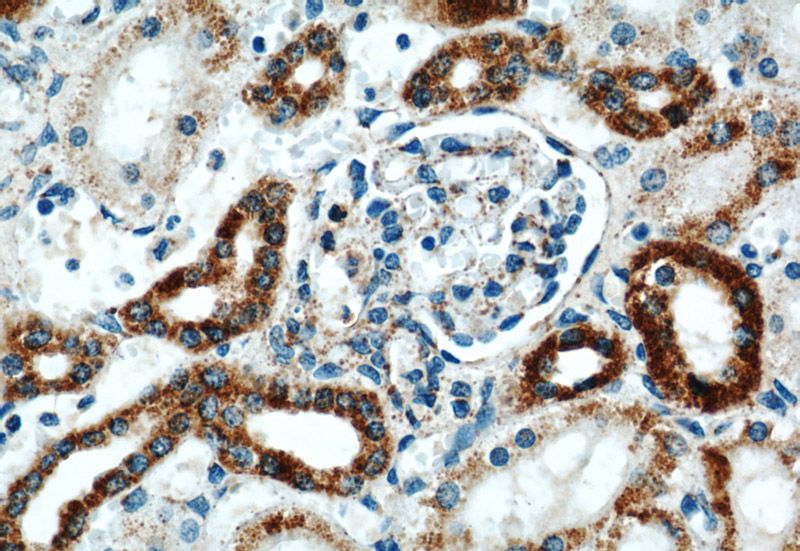
Immunohistochemistry of paraffin-embedded human kidney slide using Catalog No:108350(ATP5A1 Antibody) at dilution of 1:50

-
Product Name
ATP5A1 antibody
- Documents
-
Description
ATP5A1 Rabbit Polyclonal antibody. Positive WB detected in multi-cells/tissue, HEK-293 cells, HeLa cells, HepG2 cells, Jurkat cells, K-562 cells, MCF7 cells, mouse heart tissue, mouse liver tissue, PC-3 cells, rat heart tissue, Y79 cells. Positive IHC detected in human liver tissue, human kidney tissue. Positive IF detected in HepG2 cells, Hela cells. Observed molecular weight by Western-blot: 50-55kd
-
Tested applications
ELISA, IHC, WB, IF
-
Species reactivity
Human,Mouse,Rat; other species not tested.
-
Alternative names
ATP5A antibody; ATP5A1 antibody; ATP5AL2 antibody; ATPM antibody; hATP1 antibody; MOM2 antibody; OMR antibody; ORM antibody
-
Isotype
Rabbit IgG
-
Preparation
This antibody was obtained by immunization of ATP5A1 recombinant protein (Accession Number: NM_004046). Purification method: Antigen affinity purified.
-
Clonality
Polyclonal
-
Formulation
PBS with 0.02% sodium azide and 50% glycerol pH 7.3.
-
Storage instructions
Store at -20℃. DO NOT ALIQUOT
-
Applications
Recommended Dilution:
WB: 1:500-1:5000
IHC: 1:20-1:200
IF: 1:10-1:100
-
Validations

WB results of Catalog No:108350 (anti-ATP5A1 antibody).

Immunofluorescent analysis of HepG2 cells, using ATP5A1 antibody Catalog No:108350 at 1:25 dilution and Rhodamine-labeled goat anti-rabbit IgG (red).

Immunohistochemical of paraffin-embedded human liver using Catalog No:108350(ATP5A1 antibody) at dilution of 1:100 (under 10x lens)

Immunohistochemical of paraffin-embedded human liver using Catalog No:108350(ATP5A1 antibody) at dilution of 1:100 (under 40x lens)
Immunohistochemistry of paraffin-embedded human kidney slide using Catalog No:108350(ATP5A1 Antibody) at dilution of 1:50
Immunohistochemistry of paraffin-embedded human kidney slide using Catalog No:108350(ATP5A1 Antibody) at dilution of 1:50
-
Background
The ATP5A1 gene encodes the α subunit of mitochondrial ATP synthase which produces ATP from ADP in the presence of a proton gradient across the membrane. The mitochondrial ATP synthase, also known as Complex V or F1F0 ATP synthase, is a multi-subunit enzyme complex consisting of two functional domains, the F1-containing the catalytic core and the Fo- containing the membrane proton channel. F0 domain has 10 subunits: a,b, c, d, e, f, g, OSCP, A6L, and F6. F1 is composed of subunits α, β, γ, δ, ε, and a loosely attached inhibitor protein IF1. Recently defect in ATP5A1 has been linked to the fatal neonatal mitochondrial encephalopathy. ATP5A1 is localized in the mitochondria and anti-ATP5A1 can be used as the loading control for mitochondrial or Complex V proteins. This antibody recognizes the endogenous ATP5A1 protein in lysates from various cell lines and tissues.
-
References
- Preuss B, Berg C, Dengjel J, Stevanovic S, Klein R. Relevance of the inner mitochondrial membrane enzyme F1F0-ATPase as an autoantigen in autoimmune liver disorders. Liver international : official journal of the International Association for the Study of the Liver. 32(2):249-57. 2012.
- Plun-Favreau H, Burchell VS, Holmström KM. HtrA2 deficiency causes mitochondrial uncoupling through the F₁F₀-ATP synthase and consequent ATP depletion. Cell death & disease. 3:e335. 2012.
- Shen C, Kuang Y, Liu J. Prss37 is required for male fertility in the mouse. Biology of reproduction. 88(5):123. 2013.
- Meierhofer D, Weidner C, Hartmann L. Protein sets define disease states and predict in vivo effects of drug treatment. Molecular & cellular proteomics : MCP. 12(7):1965-79. 2013.
- Fowler SL, Akins M, Zhou H, Figeys D, Bennett SA. The liver connexin32 interactome is a novel plasma membrane-mitochondrial signaling nexus. Journal of proteome research. 12(6):2597-610. 2013.
- Kantardzhieva A, Peppi M, Lane WS, Sewell WF. Protein composition of immunoprecipitated synaptic ribbons. Journal of proteome research. 11(2):1163-74. 2012.
- Kioka H, Kato H, Fujikawa M. Evaluation of intramitochondrial ATP levels identifies G0/G1 switch gene 2 as a positive regulator of oxidative phosphorylation. Proceedings of the National Academy of Sciences of the United States of America. 111(1):273-8. 2014.
- Wang Y, Zhang Y, Zhu Y, Zhang P. Lipolytic inhibitor G0/G1 switch gene 2 inhibits reactive oxygen species production and apoptosis in endothelial cells. American journal of physiology. Cell physiology. 308(6):C496-504. 2015.
Related Products / Services
Please note: All products are "FOR RESEARCH USE ONLY AND ARE NOT INTENDED FOR DIAGNOSTIC OR THERAPEUTIC USE"
